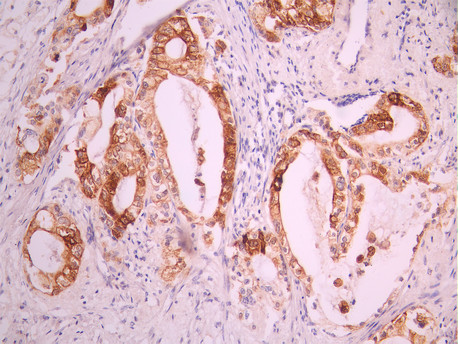

MUC5AC Recombinant Monoclonal Antibody
-
中文名稱:MUC5AC Recombinant Monoclonal Antibody
-
貨號:CSB-RA152151A0HU
-
規格:¥1320
-
圖片:
-
IHC image of CSB-RA152151A0HU diluted at 1:100 and staining in paraffin-embedded human stomach tissue performed on a Leica BondTM system. After dewaxing and hydration, antigen retrieval was mediated by high pressure in a citrate buffer (pH 6.0). Section was blocked with 10% normal goat serum 30min at RT. Then primary antibody (1% BSA) was incubated at 4°C overnight. The primary is detected by a Goat anti-rabbit polymer IgG labeled by HRP and visualized using 0.05% DAB.
-
IHC image of CSB-RA152151A0HU diluted at 1:100 and staining in paraffin-embedded human pancreatic cancer performed on a Leica BondTM system. After dewaxing and hydration, antigen retrieval was mediated by high pressure in a citrate buffer (pH 6.0). Section was blocked with 10% normal goat serum 30min at RT. Then primary antibody (1% BSA) was incubated at 4°C overnight. The primary is detected by a Goat anti-rabbit polymer IgG labeled by HRP and visualized using 0.05% DAB.
-
-
其他:
產品詳情
-
Uniprot No.:
-
基因名:
-
別名:MUC5AC antibody; MUC5 antibody; Mucin-5AC antibody; MUC-5AC antibody; Gastric mucin antibody; Major airway glycoprotein antibody; Mucin-5 subtype AC antibody; tracheobronchial antibody; Tracheobronchial mucin antibody; TBM antibody
-
反應種屬:Human
-
免疫原:A synthesized peptide from human MUC5AC protein
-
免疫原種屬:Homo sapiens (Human)
-
標記方式:Non-conjugated
-
克隆類型:Monoclonal
-
抗體亞型:Rabbit IgG
-
純化方式:Affinity-chromatography
-
克隆號:18H7
-
濃度:It differs from different batches. Please contact us to confirm it.
-
保存緩沖液:Rabbit IgG in 10mM phosphate buffered saline , pH 7.4, 150mM sodium chloride, 0.05% BSA, 0.02% sodium azide and 50% glycerol.
-
產品提供形式:Liquid
-
應用范圍:ELISA, IHC
-
推薦稀釋比:
Application Recommended Dilution IHC 1:50-1:200 -
Protocols:
-
儲存條件:Upon receipt, store at -20°C or -80°C. Avoid repeated freeze.
-
貨期:Basically, we can dispatch the products out in 1-3 working days after receiving your orders. Delivery time maybe differs from different purchasing way or location, please kindly consult your local distributors for specific delivery time.
-
用途:For Research Use Only. Not for use in diagnostic or therapeutic procedures.
相關產品
靶點詳情
-
功能:Gel-forming glycoprotein of gastric and respiratory tract epithelia that protects the mucosa from infection and chemical damage by binding to inhaled microorganisms and particles that are subsequently removed by the mucociliary system. Interacts with H.pylori in the gastric epithelium, Barrett's esophagus as well as in gastric metaplasia of the duodenum (GMD).
-
基因功能參考文獻:
- S100A12 activates NLPR3 inflammasomes to induce MUC5AC production in airway epithelial cells. ATP induces MUC5AC production in a mechanistically similar mode to S100A12. PMID: 29906464
- The results of the present study indicate that Munc132 may be an essential regulator of basal MUC5AC exocytosis, while Munc134 appears to be a Munc13 protein subtype that may to be sensitive to hNE stimulation during airway MUC5AC hypersecretion. PMID: 29767240
- resistin induced MUC5AC and MUC5B expression via activation of different signaling pathways in human airway epithelial cells. PMID: 29604272
- the splice switch to DeltaC-ZIP2 as well as decreased expression of other ZIPs caused zinc deficiency, which is sufficient for induction of MUC5AC. PMID: 29289532
- this paper shows that IL-1beta upregulates Muc5ac expression via NF-kappaB-induced HIF-1alpha in asthma PMID: 29031476
- Data suggest that secreted IL-6 regulates CLB2.0-induced MUC5AC and MUC1 expression via ROS-mediated downregulation of claudin-1 expression to maintain mucus homeostasis in the airway. PMID: 28946937
- Helicobacter pylori (H. pylori)-CagA significantly upregulated MUC5AC, MUC2, and MUC5B expression in AGS cells, but did not affect E-cadherin and MUC6 expression. PMID: 29869461
- Oct-4 expression and the reduction of MUC5AC expression may be involved in the progression and an unfavorable prognosis of GC PMID: 28762513
- smoking might decrease tear secretion, goblet cell density and tear MUC5AC concentration. PMID: 27297822
- High-Mobility Group Box 1 Upregulates MUC5AC and MUC5B Expression in Primary Airway Epithelial Cells PMID: 29286856
- Cyclic pressure did not induce MUC5AC secretion in the airway mucus epithelium via Ca(2+)-dependent ATP release, and nearly all Ca(2+) was provided by stored intracellular Ca(2). PMID: 27919041
- IL-33 induced MUC5AC mRNA and MUC5AC protein, and also goblet cell hyperplasia at air liquid interface culture in human nasal epithelial cells. In addition to that, IL-33 induced MUC5B and FOXA3, and reduces FOXJmRNA. PMID: 27776277
- MUC5AC has pathologic roles in mechanisms of allergen-induced airway hyperresponsiveness, mucous metaplasia, and airway mucus plugging. PMID: 27845589
- Leptin knockdown suppressed MUC5AC production and secretion induced by IL-13 in human bronchial epithelial cells. PMID: 28942146
- The results suggest that the analysis of expression of MUC5AC and TFF1 may be useful for differentiating sessile serrated adenomas/polyps (SSA/Ps) from hyperplastic polyps (HPs). PMID: 28430953
- The Egr-1 is essential for CSE-induced MUC5AC production in HBE cells likely through interaction with and modulation of AP-1, and re-emphasize targeting Egr-1 as a novel therapeutic strategy for COPD. PMID: 28602698
- Mucus plugs from individuals with fatal asthma are heterogeneous gels with distinct MUC5AC- and MUC5B-containing domains. Tethering of MUC5AC-containing domains to the epithelium causes mucostasis and likely represents a major cause of mucus plugging in asthma. PMID: 27183390
- The only individual marker that was found to have direct and strong correlation with the clinical outcome of ampullary carcinoma was MUC5AC (not used in the Ang or Chang panels), with statistically significant survival differences found with various cutoffs tested (for 20% cutoff, 5-y survival, 68% vs. 31%; P=0.0002). In addition, MUC5AC significantly stratified the histologically pancreatobiliary and intestinal cases. PMID: 28505002
- MUC5AC interacts with integrin beta4 that mediates phosphorylation of FAK at Y397 leading to lung cancer cell migration. PMID: 26751774
- Results show that the glycoforms of MUC5AC in mucinous cysts of the pancreas display two unusual motifs, terminal alphaGlcNAc and terminal betaGlcNAc. PMID: 27992432
- MUC5AC expression was significantly higher in pancreatic adenocarcinoma than in healthy controls and chronic pancreatitis patients. PMID: 27845339
- Cigarette smoke exposure initially triggers the production of mitoROS and subsequently elicits autophagy in airway epithelial cells, which then regulate MUC5AC expression partially through modulation of the JNK signaling and the transcription factor AP-1. PMID: 27084849
- this study shows that S-allylmercapto-l-cysteine can suppress MUC5AC secretion using the cell model of chronic obstructive pulmonary disease PMID: 27517516
- This paper aims at developing a quantitative computer-aided methodology for automated identification of mucin areas and its percentage using tissue histological images PMID: 26971129
- MUC5B was significantly more often detected in middle ear effusion fluid relative to MUC5AC. MUC5AC presence was not significantly different in mucoid and serous fluid. PMID: 27729120
- outcome, while the gain of aberrant expression of MUC5AC and particularly of MUC6 was associated with favorable outcome in colorectal cancer, notably in intermediate stages II and III PMID: 27298226
- Low mucin1 expression is associated with peritoneal dissemination of gastrointestinal cancer. PMID: 27193208
- The HNE-TACE signalling pathway has an important role in the process of MUC5AC overexpression in chronic rhinosinusitis. PMID: 26881964
- Knockdown of MUC5AC in SW620 cells remarkably suppressed cell vitality and promoted apoptosis and G1 cell cycle arrest, resulting in the impaired ability of colony formation. The inhibition of MUC5AC in SW620 cells dramatically repressed the cell migration and invasion. PMID: 27610469
- These results suggest that IFN-gamma represses MUC5AC expression, disturbing binding of Sp1 to its target sequences. PMID: 27324793
- this study shows that SYK increased MUC5AC expression via ERK2 and p38 MAPK signaling pathways in airway epithelial cells PMID: 26980390
- The interference of p38 gene expression inhibited the release of IL-1beta and TNF-alpha in cultured cells. It also depressed both mRNA and protein levels of MUC5A. PMID: 26722604
- The expression of messenger RNAs is inhibited by EGFR tyrosine kinase inhibitor PMID: 26867523
- is a major component of the mucus produced by airway epithelial cells. PMID: 26100173
- Review-Meta-analysis: decreased Muc5AC expression might be a poor prognostic predictor for gastric cancer. PMID: 26420972
- Data show that verproside inhibits tumor necrosis factor alpha-induced mucin 5AC (MUC5AC) expression through NF-kappa B pathway. PMID: 26318254
- Overexpression of MUC5AC has been described in idiopathic pulmonary fibrosis lungs. Read More: http://www.atsjournals.org/doi/full/10.1164/rccm.201507-1322LE#.V2WAGNLrtNs PMID: 26871672
- The expression of ALPi and MUC5AC in cocultures of Caco-2 and HT29 cells developed for permeability studies is reported. PMID: 26299896
- MUC5AC hypomethylation is predictive of serrated lesions with malignant potential PMID: 26476272
- EGF removal or tyrphostin AG1478 treatment of differentiating air-liquid interface cultures from asthmatic children would result in a reduction of epithelial goblet cells and mucus secretion. PMID: 26057128
- These data lend support to the notion that beta2AR-agonists may contribute to asthma exacerbations by increasing mucin production via activation of beta2ARs on epithelial cells. PMID: 26161982
- The measurement of the CA 19-9 antigen on individual proteins could improve performance over the standard CA 19-9 assay. PMID: 22220206
- Studied the effects of 15-HETE on MUC5AC expression and related pathways. PMID: 25649981
- Increased expression of MUC5AC was associated with bacterial biofilm formation in chronic rhinosinusitis patients. PMID: 25638393
- Leukotriene E4 induces MUC5AC release from human airway epithelial NCI-H292 cells PMID: 25838093
- Results showed that MUC5AC expression is correlated to the tumor stage where advanced gastric cancers present reduced levels of MUC5AC and that Gli regulates its expression via interaction with a highly conserved sequence in its promoter region. PMID: 25166306
- MUC5AC expression in ovarian mucinous tumors did not change from benign to malignant tumors. PMID: 25298197
- Common genetic variations in the MUC5AC gene are not related to helicobacter pylori serologic status. PMID: 25605164
- The genetic length variants in the central repetitive region of MUC5AC were not associated with meconium ileus in cystic fibrosis. PMID: 24920497
- Data suggest that determination of mucin 5AC (MUC5AC) methylation status may be useful for understanding and predicting the natural history of colorectal cancers (CRC). PMID: 25403854
顯示更多
收起更多
-
亞細胞定位:Secreted.
-
組織特異性:Highly expressed in surface mucosal cells of respiratory tract and stomach epithelia. Overexpressed in a number of carcinomas. Also expressed in Barrett's esophagus epithelium and in the proximal duodenum.
-
數據庫鏈接:
Most popular with customers
-
-
YWHAB Recombinant Monoclonal Antibody
Applications: ELISA, WB, IHC, IF, FC
Species Reactivity: Human, Mouse, Rat
-
Phospho-YAP1 (S127) Recombinant Monoclonal Antibody
Applications: ELISA, WB, IHC
Species Reactivity: Human
-
-
-
-
-